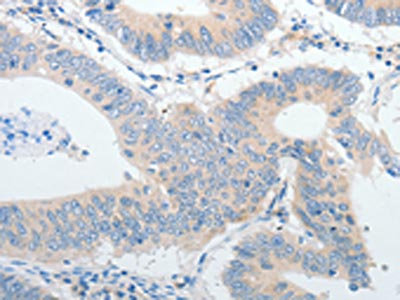

IGFBP1 Antibody
-
中文名稱:IGFBP1兔多克隆抗體
-
貨號(hào):CSB-PA197609
-
規(guī)格:¥1100
-
圖片:
-
The image on the left is immunohistochemistry of paraffin-embedded Human liver cancer tissue using CSB-PA197609(IGFBP1 Antibody) at dilution 1/30, on the right is treated with synthetic peptide. (Original magnification: ×200)
-
The image on the left is immunohistochemistry of paraffin-embedded Human colon cancer tissue using CSB-PA197609(IGFBP1 Antibody) at dilution 1/30, on the right is treated with synthetic peptide. (Original magnification: ×200)
-
Gel: 10%SDS-PAGE, Lysate: 30 μg, Lane: Mouse liver tissue, Primary antibody: CSB-PA197609(IGFBP1 Antibody) at dilution 1/550, Secondary antibody: Goat anti rabbit IgG at 1/8000 dilution, Exposure time: 1 minute
-
-
其他:
產(chǎn)品詳情
-
Uniprot No.:
-
基因名:
-
別名:AFBP antibody; Alpha pregnancy associated endometrial globulin antibody; Amniotic fluid binding protein antibody; Binding protein 25 antibody; Binding protein 26 antibody; Binding protein 28 antibody; Growth hormone independent binding protein antibody; hIGFBP 1 antibody; hIGFBP1 antibody; IBP 1 antibody; IBP-1 antibody; IBP1 antibody; IBP1_HUMAN antibody; IGF binding protein 1 antibody; IGF BP25 antibody; IGF-binding protein 1 antibody; IGFBP 1 antibody; IGFBP-1 antibody; IGFBP1 antibody; Insulin like growth factor binding protein 1 antibody; Insulin-like growth factor-binding protein 1 antibody; Placental protein 12 antibody; PP 12 antibody; PP12 antibody
-
宿主:Rabbit
-
反應(yīng)種屬:Human,Mouse
-
免疫原:Synthetic peptide of Human IGFBP1
-
免疫原種屬:Homo sapiens (Human)
-
標(biāo)記方式:Non-conjugated
-
抗體亞型:IgG
-
純化方式:Antigen affinity purification
-
濃度:It differs from different batches. Please contact us to confirm it.
-
保存緩沖液:-20°C, pH7.4 PBS, 0.05% NaN3, 40% Glycerol
-
產(chǎn)品提供形式:Liquid
-
應(yīng)用范圍:ELISA,WB,IHC
-
推薦稀釋比:
Application Recommended Dilution ELISA 1:2000-1:10000 WB 1:1000-1:5000 IHC 1:25-1:100 -
Protocols:
-
儲(chǔ)存條件:Upon receipt, store at -20°C or -80°C. Avoid repeated freeze.
-
貨期:Basically, we can dispatch the products out in 1-3 working days after receiving your orders. Delivery time maybe differs from different purchasing way or location, please kindly consult your local distributors for specific delivery time.
-
用途:For Research Use Only. Not for use in diagnostic or therapeutic procedures.
相關(guān)產(chǎn)品
靶點(diǎn)詳情
-
功能:IGF-binding proteins prolong the half-life of the IGFs and have been shown to either inhibit or stimulate the growth promoting effects of the IGFs on cell culture. They alter the interaction of IGFs with their cell surface receptors. Promotes cell migration.
-
基因功能參考文獻(xiàn):
- In patients with acute myocardial infarction without previously known diabetes, high insulin-like growth factor-binding protein 1 was associated with long-term all-cause and cancer mortality but not with cardiovascular events. PMID: 29992830
- Study shows that the 3'-untranslated region of IGFBP1 mRNA is targeted by miR-542-3p. The results suggest that miR-542-3p plays an important role in endometrial decidualization by regulating the expression of major decidual marker genes. PMID: 28051155
- we demonstrated that IGFBP-1 suppress the migration of BGC-823 gastric cancer cells and play a protective role in the process of H. pylori-induced gastric cancer. PMID: 28864349
- hIGFBP1 affects endothelial cell responses and acceleration of endothelial regeneration in transgenic mouse model. PMID: 29186427
- Vaginal PAMG-1 in patients with a cervical length of 15-30 mm is highly predictive of imminent spontaneous preterm delivery. PMID: 28613021
- There was underexpression of the majority of genes after sunitinib treatment. The lower expression levels of IGFBP1, CCL20, CXCL6 and FGB were confirmed by qRT-PCR in all cases. The downregulation of gene expression leads us to search for methylation as a mechanism of action of the tyrosine kinase inhibitors PMID: 27834463
- A panel consisting of IGFBP1, KIM1, GCLC and GSTM1 genes could be used in combination for early screening of CKDu, whereas these genes in addition with FN1, IGFBP3 and KLK1 could be used to monitor progression of CKDu. The regulation of these genes has to be studied on larger populations to validate their efficiency for further clinical use. PMID: 28103909
- We report interactions between CSNK-2beta and IGFBP-1 as well as mTOR and CSNK-2beta, providing strong evidence of a mechanistic link between mTOR and IGF-I signaling, two critical regulators of cell growth via CSNK-2. PMID: 29037858
- We conclude that low BDNF and high LCN2 and NF-L levels are associated with Multiple Sclerosis (MS) pathogenesis, and high IGFBP1level is a biomarker for female MS only, suggesting different MS progression pathways between the sexes. LCN2 is a candidate predictor of response to natalizumab treatment, and NF-L is a candidate predictor of clinically isolated syndrome's (CIS) conversion into MS. PMID: 29108879
- Results show that IGFBP-1 transcription and FoxO1 expression are dysregulated in tamoxifen-resistant cancer cells. PMID: 28096479
- IGBFBP-1 levels increased significantly in type 2 diabetic patients with acute coronary syndrome on sitagliptin. PMID: 27190088
- Women with higher IGFBP-1 were more likely to have a low relative muscle mass. PMID: 28732569
- Levels of serum IGFBP-1 were shown to be significantly higher in patients with NPCs. PMID: 28143425
- Levels of blood IGFBP-1 in pre- and post-menopausal rheumatoid arthritis patients were significantly higher in comparison to the control group. PMID: 27775453
- ALDH1A1 and IGFBP1 are differentially overexpressed in CLM and may play a dual role, functioning as both tumor suppressors and metastasis promoters in CRC PMID: 27152521
- Moreover, a prospective human study showed that having high IGFBP1 levels reduces the risk of developing type-2 diabetes by more than 85%. PMID: 27516442
- Study provides evidence that elevated values of IGFBP -1 in cervical secretion are highly correlated with preterm labor. PMID: 27452330
- IGFBP1 levels were higher in patients with multivessel than those with single-vessel lesions; Circulating IGFBP1 level positively correlated with the severity of coronary artery disease. PMID: 28316362
- The reduced affinity of fibrinogen for IGFBP-1 accompanying diabetes may potentially shift the equilibrium to liberate more IGFBP-1 PMID: 27919172
- Plasma IGFBP-1 was significantly associated with plasma EPO concentration in acute kidney injury, suggesting an unknown mechanism related to systemic stress conditions for EPO regulation in AKI. PMID: 26479890
- Results show that fibrinogen forms complexes with IGFBP-1 under physiological conditions. Several experimental approaches have confirmed that complexes are co-isolated with fibrinogen from plasma, they are relatively stable, and they appear as a general feature of human plasma. PMID: 27260393
- Serum IGFBP-1 and -2 are increased in idiopathic pulmonary fibrosis and IGFBP-2 may be reduced by anti-fibrosing therapy. PMID: 27215343
- The reference change values values for serum IGFBP-1 were 59.9%, 83.2% and 93.0% and for fasting serum insulin were 68.5%, 79.0% and 93.4% for subjects with normal glucose tolerance, impaired fasting glucose, and impaired glucose tolerance, respectively. PMID: 23548151
- mTOR inhibition constitutes a mechanistic link between hypoxia, reduced IGF-I bioavailability and fetal growth retardation. PMID: 26714229
- the hepatokine IGFBP1 is a critical liver-bone hormonal relay that promotes osteoclastogenesis and bone resorption as well as an essential mediator of FGF21-induced bone loss PMID: 26456333
- There was a positive correlation between the IGFBP1 levels of and those of inflammatory mediators in HIV Infections. PMID: 25890304
- trend towards higher cord blood values in intrauterine growth restriction observed PMID: 26118397
- The amino acid response and mTOR independently regulate IGFBP-1 secretion and phosphorylation in response to decreased amino acid availability. PMID: 25957086
- Insulin-like growth factor 1 receptor blockade can inhibit glioblastoma growth by different mechanisms, including direct effects on the tumor cells as well as indirect anti-angiogenic effects. PMID: 25543125
- gene expression analysis of human breast tumors showed that high expression of IGFBP mRNA was strongly correlated with good prognosis but not when MMP9 mRNA was also highly expressed PMID: 26025665
- study shows up-regulation of MCSF in GBM via a SYK-PI3K-NFkappaB-dependent mechanism and identifies IGFBP1 released by microglial cells as a novel mediator of MCSF-induced angiogenesis PMID: 26245897
- Activation of IGFBP1 by pregnane X receptor alters the morphology of hepatocellular carcinoma cells and regulates cell migration. PMID: 26232425
- IGFBP1 in epithelial circulating tumor cells as a potential response marker to selective internal radiation therapy in hepatocellular carcinoma PMID: 25123037
- Data suggest that expression of IGFBP1 in hepatocytes can be regulated by carnosine, a dietary factor; carnosine down-regulates expression of IGFBP1 in Hep G2 cells; mechanism involves suppression of HIF1A (hypoxia inducible factor 1 alpha subunit). PMID: 25869614
- Suggest that IGFBP-1 inhibits the invasion and metastasis of HCC cells and that IGFBP-1 may be useful as a valuable marker for the prognosis of patients with HCC. PMID: 25337205
- Variations in relative quantities of IGFBP-1 monomers and complexes in different tumor types were much more pronounced than those of IGFBP-2. PMID: 25746666
- term placental explants, but not their conditioned medium, can de-phosphorylate IGFBP-1 through the action of placental alkaline phosphatase PMID: 24856042
- The predictive value of IGFBP1 in cervical secretion as bedside test for prediction of preterm labor in symptomatic women was studied. PMID: 25597167
- Data suggest that up-regulation of IGFBP1 in vaginal smears (as a biological marker for presence of amniotic fluid) may be useful point-of-care test for diagnosis of premature rupture of fetal membranes. PMID: 24612210
- In the second trimester, rapid cervical phIGFBP-1 testing in asymptomatic twin pregnancies has a poor performance in predicting spontaneous preterm delivery PMID: 24436153
- This paper provides a brief overview of the structure and regulation of IGFBP-rP1 and its various biological functions in cancer--{review} PMID: 24513543
- DeltaIGFBP-1 as a biomarker of hepatic insulin resistance PMID: 24056811
- According to this study IGFBP-1 is a specific marker for preterm delivery in pregnant women with clinical symptoms. PMID: 24919336
- Amniotic fluid samples collected after labour onset contained proteolytic activity that generated 12- and 19-kDa IGFBP-1 fragments that did not bind to 125I-IGF-I. This activity was not detected in amniotic fluid collected prior to labour onset. PMID: 23183724
- Serum glycodelin levels did not predict endometrial receptivity in patients undergoing in vitro fertilization. PMID: 23585335
- Pyridoxal may induce the expression of IGFBP1 in hepatoma cells via a mechanism involving the ERK/cJun pathway. PMID: 23942851
- elevated insulin-like growth factor binding protein 1 appears to be associated with shorter time to castration resistant prostate cancer and lower overall survival in men with metastatic prostate cancer PMID: 24132762
- C/EBPbeta regulates the expression of IGFBP-1 and PRL by altering the histone acetylation status of their promoters but differently regulates Mn-SOD gene expression in human ESC during decidualization PMID: 24248464
- The median concentrations of first-trimester vaginal and cervical phIGFBP-1 are higher in women with spontaneous preterm delivery at <32 and <37 weeks gestation. PMID: 23408645
- FOXO1/IGFBP-1 axis is essential for PRB-dependent growth inhibition of endometrial epithelial cells PMID: 23603247
顯示更多
收起更多
-
亞細(xì)胞定位:Secreted.
-
數(shù)據(jù)庫(kù)鏈接:
Most popular with customers
-
-
YWHAB Recombinant Monoclonal Antibody
Applications: ELISA, WB, IHC, IF, FC
Species Reactivity: Human, Mouse, Rat
-
Phospho-YAP1 (S127) Recombinant Monoclonal Antibody
Applications: ELISA, WB, IHC
Species Reactivity: Human
-
-
-
-
-